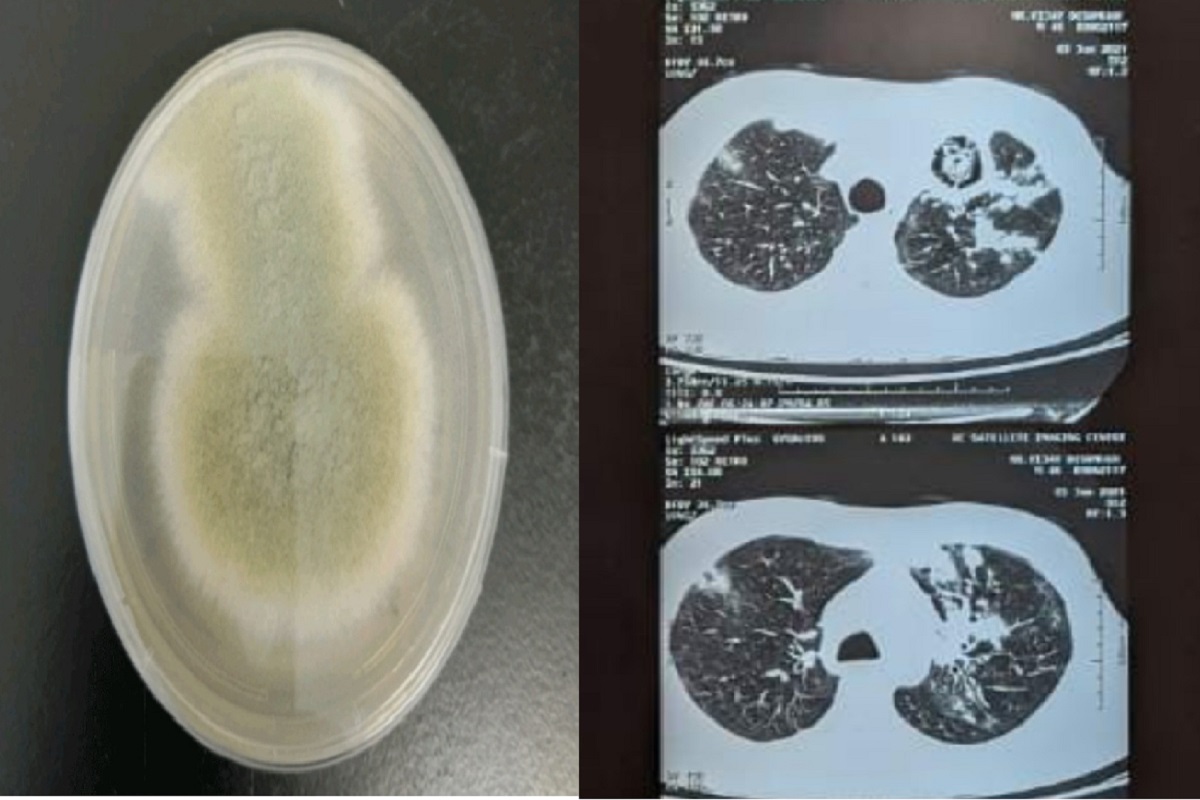
कोरोना, म्युकरमायकोसिस, बोन डेथ आणि आता ग्रीन फंगस; मुंबईवर आजारांचं संकट

मुंबई, 06 जुलै : कोरोनाचा सर्वाधिक फटका बसलेल्या मुंबईने (Coronavirus in Mumbai) पहिल्या आणि दुसऱ्या लाटेवर बऱ्यापैकी नियंत्रण मिळवलं. तिसऱ्या लाटेशीही दोन हात करण्याची तयारी मुंबईने सुरू केली आहे. अशात मुंबईवरील आजारांचं संकट काही संपेना. एकामागोमाग एक आजार येतच आहेत. कोरोनाव्हायरसनं इतर नवीन आजार समोर येत आहे. कोरोनाव्हायरसनंतर म्युकरमायकोसिस, बोन डेथ (Bone death) आणि आता ग्रीन फंगसचे (Green fungus) रुग्ण सापडले आहेत. मुंबईत ग्रीन फंगस (Green fungus case in Mumbai) म्हणजे हिरव्या बुरशीचे रुग्ण आढळून आले आहेत. केईएममध्ये आतापर्यंत 8 रुग्णांवर उपचार झाले. कोरोनातून बऱ्या झालेल्या रुग्णांना ग्रीन फंगसची लागण हो आहे. केईएम रुग्णालयाचे अधिष्ठाता डॉ. हेमंत देशमुख यांनी सांगितलं, याला वैद्यकीय भाषेत ऍस्परजिलस म्हटलं जातं. ही हिरवी बुरशी म्युकरमायकोसिस पेक्षाही भयानक आहे. थेट फुप्फुसातील रक्तवाहिन्यांवर अटॅक करून फुप्फुस निकाम करते. एखाद्या पक्षाच्या घरट्याप्रमाणे हे फुप्फुसावर आपलं जाळ तयार करतं. हे वाचा - आश्चर्य! कोरोना लस घेतल्यानंतर डोळ्यांची दृष्टी परत आली; आजींनी केला दावा खोकला आणि त्यातून रक्त येणं हे याचं सुरुवातीचं लक्षण आहे. फुप्फुसात रक्तस्त्रावामूळे रुग्ण अत्यवस्थ होतो. कोविड झाल्याची जाणीव नसलेल्या अनेक रुग्णांनाही याची बाधा झाली आहे, असंही ते म्हणाले. मुंबईत सापडले बोन डेथचे रुग्ण बोन डेथ ज्याला वैद्यकीय भाषेत अव्हॅस्कुलर नेक्रॉसिस किंवा डेथ ऑफ बोन टिश्युज (Avascular Necrosis or Death of Bone Tissues) म्हटलं जातं. मुंबईतील 40 वर्षांहून कमी वय असलेल्या तीन रुग्णांमध्ये ही समस्या दिसून आली आहे. कोविडवरील उपचार घेतल्यानंतर 2 महिन्यांनी अव्हॅस्कुलर नेक्रॉसिसची लक्षणं दिसलेल्या 40 वर्षांखालील 3 रुग्णांवर माहिममधील हिंदुजा हॉस्पिटलमधील डॉक्टरांनी उपचार केले आहेत. हे वाचा - कोरोनामुक्त महिलेला बळावली अशी समस्या; पाहून डॉक्टरही झाले हैराण मुंबईतील या प्रकरणांबाबत आयसीएमआरचे महासंचालक बलराम भार्गव यांनी सांगितलं की, कोरोनामुळे रक्ताच्या गुठळ्या होतात. त्यामुळे या रुग्णांना ब्लड थिनर म्हणजे रक्त पातळ करणारी औषधं दिली जातात. त्यामुळे बोन डेथची शक्यता वाढते. अशी प्रकरणं समोर येऊ शकतात.
मराठी बातम्या, ब्रेकिंग न्यूज मराठीत सर्वात आधी News18 लोकमतवर. आजच्या ताज्या बातम्या, लाइव्ह न्यूज अपडेट, सर्वात आधी वाचा विश्वासार्ह मराठी न्यूज वेबसाइट News18 लोकमतवर.
)







